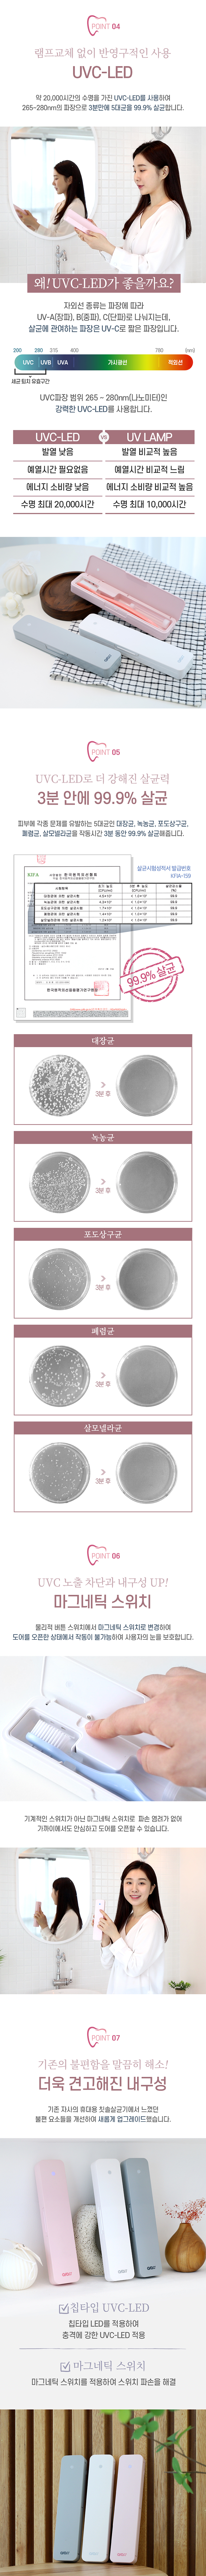

용도별 추천상품




* 기본수량 이하 소량구매 가능 여부는 당사 콜센터로 문의하시기 바랍니다.
* 배송비, 인쇄비, 특별제작의 경우에도 별도로 문의주시기 바랍니다.
* 회원가입후 이용하시면 2% 할인됩니다.
| 수량(개) | 2,500 | 1,500 | 500 | 300 | 200 | 100 | 50 |
|---|---|---|---|---|---|---|---|
| 단가(원) | 9,200 | 9,360 | 9,600 | 10,000 | 10,240 | 10,560 | 10,800 |
| 회원가(원) | 9,016 | 9,173 | 9,408 | 9,800 | 10,036 | 10,349 | 10,584 |
| 구성 | 칫솔살균기 | 제품규격 | 220*51*26mm / 125g |
|---|---|---|---|
| 제품재질 | ABS | 색상 | 화이트, 핑크, 그레이 |
| 인쇄옵션 | 별도문의 | 포장 | 별도문의 |
| 원산지 | 대한민국 | 법적허가사항 | 전자파인증, 배터리인증 |
| 제작기간 | 디자인 시안확정 후 3일~5일 | 배송정보 | 100 |

| 상품군 | 소형전자(MP3/전자사전등) |
|---|---|
| A/S 책임자와 전화번호 | 판촉통 : 1544-8759 |